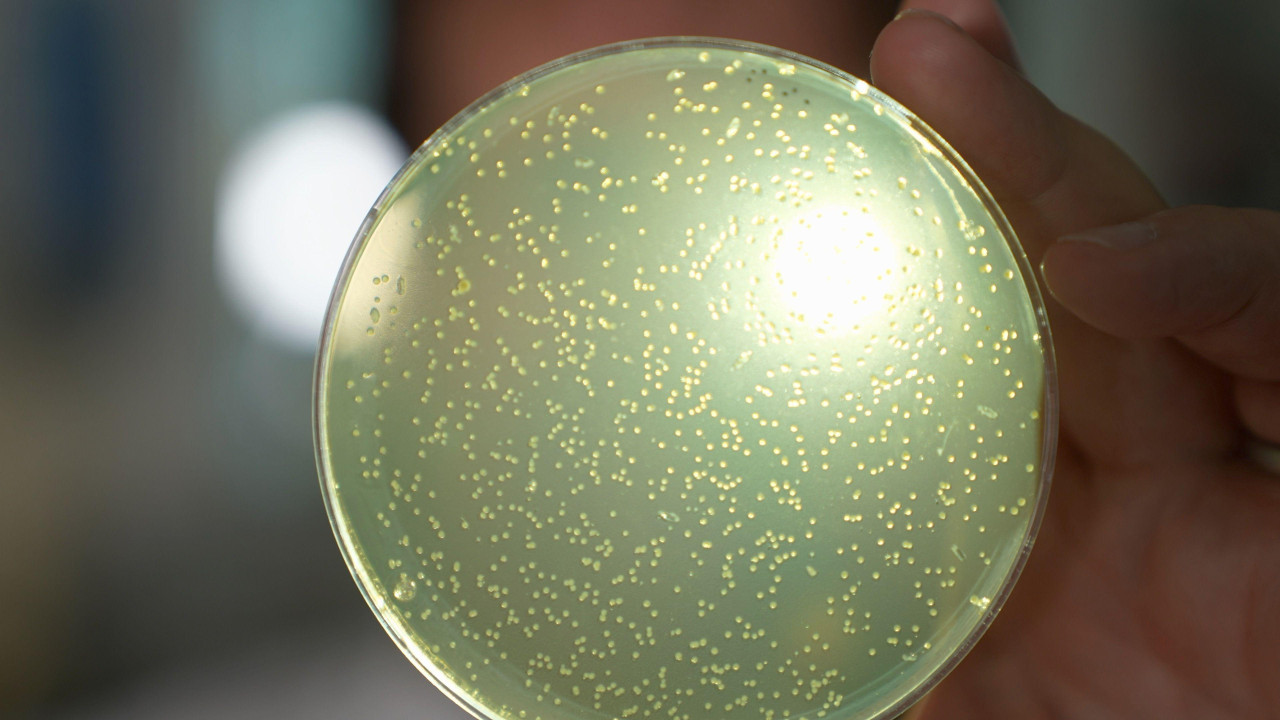
Naučnici će početi da prave alatke za stvaranje sve krupnijih delova ljudske DNK

BBC News
Otpočeo kontroverzni projekat za izradu veštačkog DNK čoveka

ilustracija DNK
Tehnologija će omogućiti istraživačima do sada neviđenu kontrolu nad ljudskim živim sistemima.

Započeo je rad na kontroverznom projektu izrade gradivnog tkiva ljudskog života od nule, za šta se veruje da je prvi poduhvat takve vrste na svetu.
Ovo istraživanje bilo je tabu tema sve do sada zbog zabrinutosti da bi moglo da dovede do dizajniranih beba ili nepredviđenih promena kod budućih generacija.
Ali sada je najveća medicinska dobrotvorna ustanova na svetu Velkam Trast izdvojila prvobitnih 10 miliona funti za početak projekta i tvrdi da on ima potencijal da učini više dobra nego štete ubrzavši lečenje mnogih neizlečivih bolesti.
Doktor Džulijan Sejl, iz MRC Laboratorije za molekularnu biologiju na Kembridžu, koji je deo ovog projekta, rekao je za BBC njuz da je ovo istraživanje sledeći ogromni korak u biologiji.
„Nebo je granica. Proučavamo terapije koje će unaprediti živote ljudi kako stare, koje će dovesti do zdravijeg starenja sa manje bolesti za ljude kako budu bili stariji.
„Želimo da iskoristimo ovaj pristup za generisanje ćelija otpornih na bolesti, koje možemo da iskoristimo da ponovo njima nastanimo oštećene organe, na primer u jetri ili srcu, pa čak i u imunom sistemu", kaže on.
Ali kritičari se plaše da će istraživanje otvoriti put beskrupuloznim istraživačima koji žele da stvore unapređene ili modifikovane ljude.
Doktor Pet Tomas, direktor grupe za kampanje Bijond GM, rekao je: „Volimo da mislimo da su svi naučnici tu da bi činili dobra, ali nauka može biti prenamenjena tako da čini zlo i da se koristi za ratovanje."
Detalji projekta poslati su BBC njuzu na uvid na 25. godišnjicu završetka Projekta ljudskog genoma, koji je izmapirao molekule u ljudskoj DNK i koji je takođe u velikoj meri finansirao Velkam.
- „Mi nismo bogovi, mi smo programeri”
- Kako genetika određuje naše životne izbore
- „Uređivanjem“ DNK do uklanjanja genetskih defekata
Svaka ćelija u našem telu sadrži molekul zvani DNK sa genetskim informacijama koje su mu potrebne.
DNK je napravljen od samo četiri mnogo manjih gradivnih blokova koji se nazivaju A, G, C i T, a koji se ponavljaju iznova i iznova u raznim kombinacijama.
Neverovatno, ali ona sadrži sve genetske informacije koje nas fizički čine onim što jesmo.
Projekat ljudski genoma je omogućio naučnicima da očitaju sve ljudske gene poput barkoda.
Novi rad koji upravo započinje, nazvan Projekat sintetičkog ljudskog genoma, potencijalno pravi ogroman korak napred – omogućivši istraživačima ne samo da očitaju molekule DNK, već i da stvaraju njene delove, možda jednog dana i u celosti, molekul po molekul, od nule.
Prvi cilj naučnika je da razviju načine za izgradnju sve većih građevinskih blokova ljudske DNK, sve do tačke kad budu sintetički konstruisali ljudski hromozom.
On sadrži gene koji upravljaju našim razvojem, popravkama i održavanjem.
Oni će tada moći da ih prouče i da na njima eksperimentišu kako bi saznali više o tome kako geni i DNK regulišu naša tela.
Do mnogih bolesti dolazi kad se ovi geni pokvare i zato bi studije mogle da dovedu do boljeg lečenja, prema profesoru Metjuu Herlsu, direktoru Instituta Velkam Sanger, koji je sekvencirao najveće delove Ljudskog genoma.
„Stvaranje DNK od nule omogućava nam da testiramo kako naša DNK zaista funkcioniše i da isprobamo nove teorije, zato što trenutno možemo to da radimo samo modifikujući DNK u DNK koja već postoji u živim sistemima."

Rad projekta biće ograničen na epruvete i posude, i neće biti pokušaja stvaranja sintetičkog života.
Ali tehnologija će omogućiti istraživačima do sada neviđenu kontrolu nad ljudskim živim sistemima.
I iako projekat traži medicinske prednosti, ništa neće moći da spreči beskrupulozne naučnike da zloupotrebe ovu tehnologiju.
Oni bi, na primer, mogli da pokušaju da naprave biološko oružje, poboljšane ljude ili čak stvorenja koja imaju ljudsku DNK, prema profesoru Bilu Ernšou, izuzetno cenjenom genetskom naučniku sa Univerziteta u Edinburgu koji je dizajnirao metod za stvaranje veštačkih ljudskih hromozoma.
„Duh je pušten iz boce.
„Možemo da usvojimo set ograničenja sada, ali ako neka organizacija koja ima pristup odgovarajućoj mašineriji odluči da počne da sintetiše bilo šta, mislim da ne bismo mogli da je zaustavimo", rekao je on za BBC njuz.
Tomas se brine da će tehnologija biti komercijalizovana od zdravstvenih kompanija koje će nuditi lečenje na osnovu ovog istraživanja.
„Ako budemo uspeli da stvorimo sintetičke delove tela ili čak sintetičke ljude, onda ko će biti njihov vlasnik? A ko je vlasnik podataka iz tih kreacija?"
Imajući u vidu potencijal za zloupotrebu tehnologije, pravo pitanje za Velkam je zašto su se odlučili da je uopšte finansiraju.
Ova odluka nije doneta olako, prema doktoru Tomu Kolinsu, koji je odobrio finansiranje.
„Zapitali smo se koja je cena nedelanja.
„Ova tehnologija će svakako jednog dana biti razvijena i zato ako to budemo uradili sada, mi se makar trudimo da to uradimo na odgovoran način i da bismo kontrolisali etička i moralna pitanja na što otvoreniji mogući način", rekao je on za BBC njuz.
Specijalizovani program društvene nauke odvijaće se u tandemu sa naučnim razvojem projekata i vodiće ga profesorka Džoj Džang, sociološinja, na Univerzitetu u Kentu.
„Želimo da dobijemo stavove eksperata, socijalnih naučnika, a naročito javnosti, o tome šta oni misle o ovoj tehnologiji i kako ona može biti od koristi za njih i, najvažnije od svega, koja pitanja i koje brige imaju", kaže ona.
Pratite nas na Fejsbuku, Tviteru, Instagramu, Jutjubu i Vajberu.
Ako imate predlog teme za nas, javite se na [email protected]
- Kako DNK drevnih bakterija i virusa može da koristi današnjoj medicini
- Revolucionarno saznanje - prvi put otkriven čitav ljudski genom
- Pronađena „DNK levorukih“ - koja menja strukturu mozga
- Naučnice osvojile Nobelovu nagradu za hemiju za „makaze" koje menjaju gene
- Poklonila sam DNK - mogu li da je dobijem nazad
- DNK otkriva ko je izgradio Stounhendž




